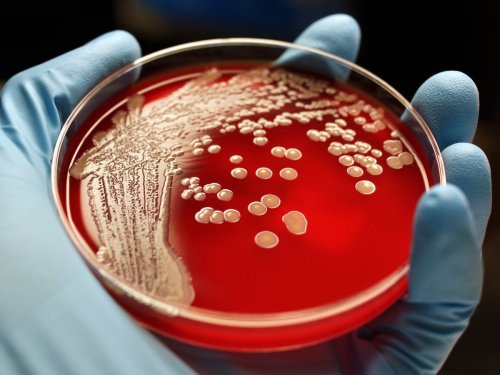

По статистике, от 50 до 90% женщин хотя бы раз в жизни сталкивались с циститом. Нередко цистит становится рецидивирующим заболеванием (если появляется три раза в год).
Что такое цистит
Цистит – это воспаление мочевого пузыря (а точнее – его слизистой оболочки). Цистит бывает и у женщин, и у мужчин. Но из-за особенностей анатомического строения (короткий мочеиспускательный канал, в который легче проникают бактерии), конечно, чаще это заболевание бывает у женщин. У мужчин цистит в основном бывает из-за каких-то сопутствующих заболеваний. В 90% случаев цистит вызывает кишечная палочка.
Почему цистит у мужчин бывает редко
Цистит у мужчин бывает реже, чем у женщин, в силу анатомических особенностей строения их мочеполовой системы:
- Длина уретры (она у мужчин длиннее, чем у женщин, поэтому бактериям сложнее проникнуть в мочевой пузырь).
- Анатомическая структура (уретра у мужчин проходит через простату, секрет которой препятствует проникновению бактерий).
- Особенности физиологии (уретра и анальное отверстие у мужчин находятся дальше друг от друга, чем у женщин, поэтому риск занесения кишечной палочки в мочевые пути намного ниже).
Симптомы цистита
Среди признаков цистита – такие:
- частые позывы в туалет небольшими порциями;
- боль при мочеиспускании и внизу живота;
- усиление боли непосредственно при мочеиспускании.
Симптомы цистита и других проблем (например, гинекологических или мочекаменной болезни) похожи, поэтому врачу важно поставить точный диагноз. Если это все-таки цистит, а не что-то более серьезное, врач отправляет пациента сдать общий анализ мочи. Если нужно будет, потом проводятся и другие обследования.

Какие анализы сдают при цистите и как расшифровать результаты
При подозрении на цистит нужно сдать такие анализы:
- общий анализ мочи (он покажет наличие или отсутствие воспалительного процесса);
- бакпосев мочи (по нему можно определить, какие именно бактерии стали причиной цистита).
Если в моче есть такие изменения, то у пациента цистит:
- большое количество лейкоцитов (такое бывает при инфекциях мочеполовой системы);
- повышенный уровень эритроцитов (указывает на то, что слизистая повреждена);
- наличие в моче нитритов и патогенных организмов (продуктов, выделяемых бактериями);
- повышенная кислотность мочи (при норме – 5-7 pH).
Но помните, что анализ мочи на цистит может быть ложным, если не соблюдены правила подготовки к сдаче. Перед сдачей мочи нужно тщательно подмыться с мылом. Если приходится сдавать мочу на цистит во время месячных, обязательно воспользуйтесь тампоном. Если вы принимаете противовоспалительные препараты или антибиотики, тоже могут быть искаженные результаты. И помните: моча на анализ должна быть свежей.
Читайте также Топ-5 таблеток от цистита
Может ли быть цистит из-за переохлаждения
Цистит вызывают бактерии, а переохлаждение может ослабить иммунитет. Если иммунитет в норме, то специальный слой внутри мочевого пузыря не дает бактериям прикрепляться на слизистой. Но как только иммунитет ослабляется, этот механизм начинает давать сбой – бактерии проникают в слизистую.
Можно ли лечить цистит толокнянкой
Если у вас острый цистит, лучше не экспериментировать и использовать традиционное эффективное лечение – антибиотики и уросептики. Но если цистит хронический, можно курсами пропивать и травы (например, толокнянку) для профилактики рецидивов заболевания.
